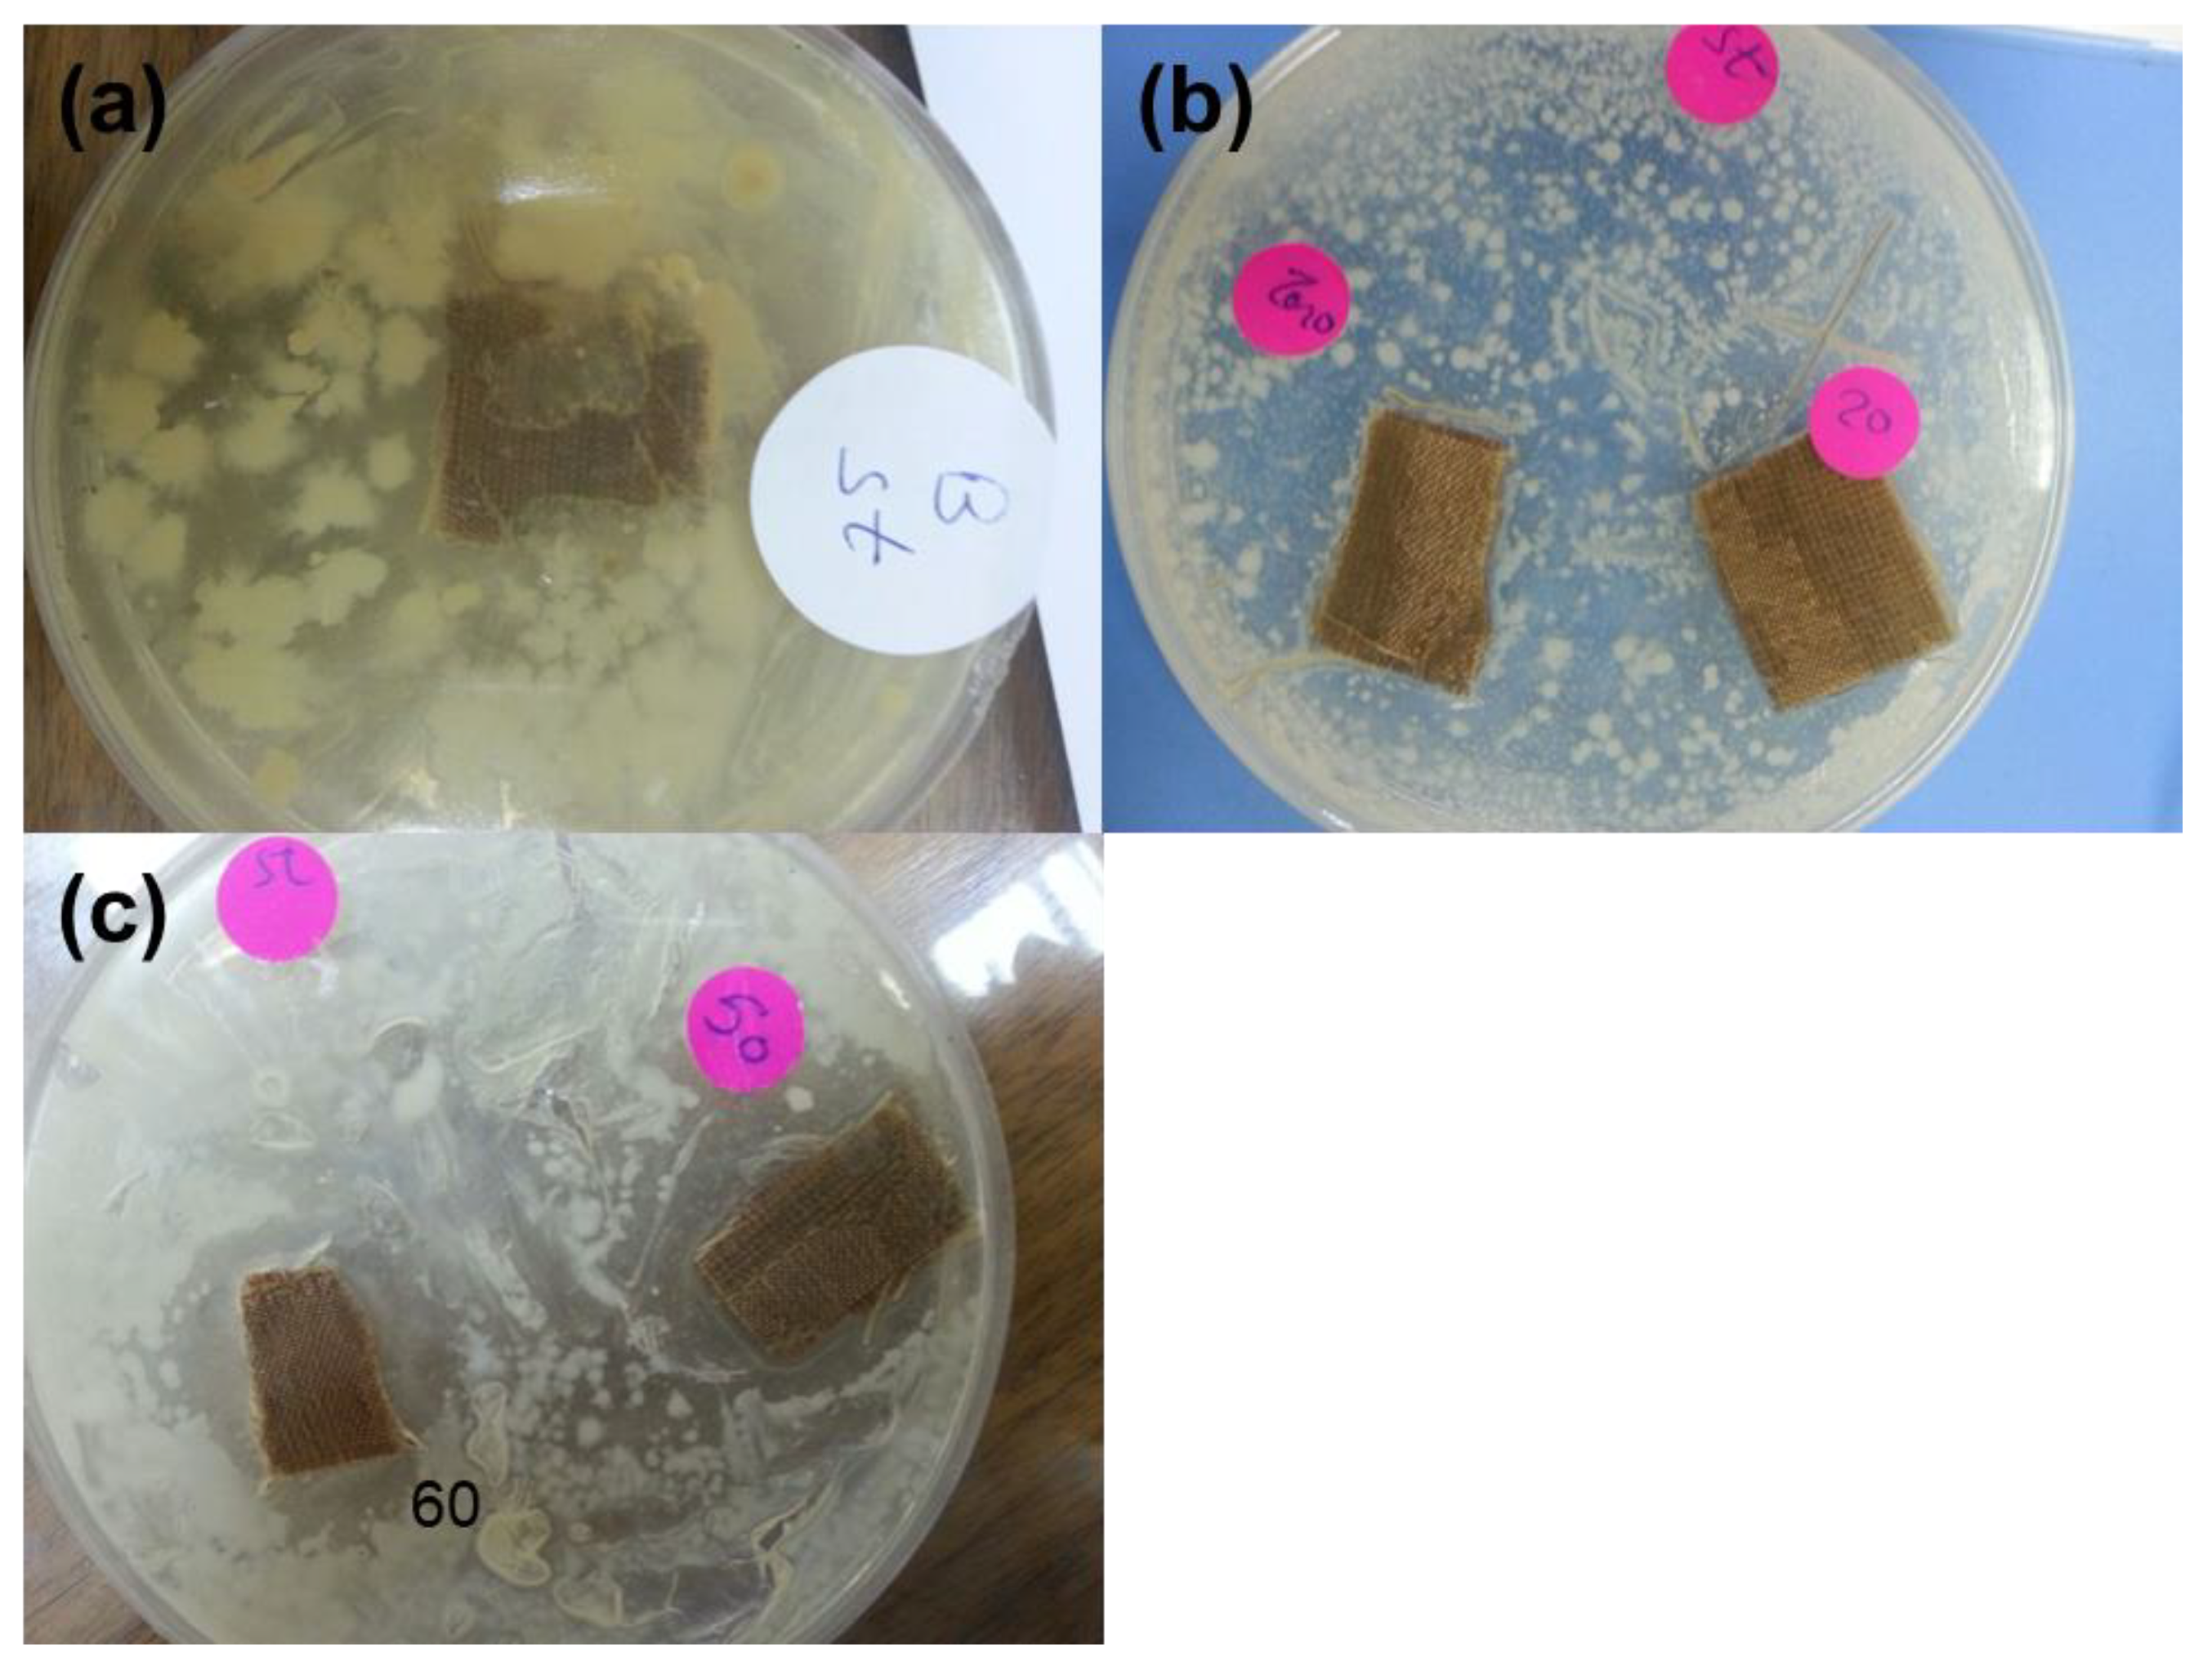
Coatings 10 00576 g004 Coatings 10 00576 g004

Facile Route for Synthesis of Novel Flame Retardant, Reinforcement and Antibacterial Textile Fabrics Coatings
Abstract
1. Introduction
2. Experimental Section
2.1. Materials
2.2. Synthesis of 2-[3-(4-methoxy-3-methylphenyl)-3-oxoprop-1-enyl]-4H-3,1-benzoxazin-4-one
2.3. Synthesis of N-[2,3-dibromo-4-(4-methoxy-3-methylphenyl)-4-oxobutanoyl]anthranilic acid (OA)
2.4. Synthesis Coating Composite for Furniture Textile Fabrics (CH–OA)
2.5. Treatment of Furniture Fabrics with Coating Layer (T–CH–OA)
2.6. Characterization
3. Results and Discussion
3.1. Structural Characterization of Developed Organic Agent (OA)
3.1.1. 2-[3-(4-methoxy-3-methylphenyl)-3-oxoprop-1-enyl]-4H-3,1-benzoxazin-4-one (2)
3.1.2. N-[2,3-dibromo-4-(4-methoxy-3-methylphenyl)-4-oxobutanoyl]anthranilicacid (Organic Agent: OA)
3.2. Characterization of Developed Coated Textile Fabrics
3.3. Thermal Stability and Flammability Properties
3.4. Mechanical and Antibacterial Properties of Developed Textile Fabrics
4. Conclusions
Supplementary Materials
Author Contributions
Funding
Conflicts of Interest
References
- Singh, M.K.; Varum, V.K.; Behera, B.K. Cosmetotextiles: State of Art; Fiber and Textiles: Łódź, Poland, 2011; pp. 27–33. [Google Scholar]
- Foksowicz-Flaczyk, J.; Walentowska, J.; Przybylak, M.; Maciejewski, H. Multifunctional durable properties of textile materials modified by biocidal agents in the sol-gel process. Surf. Coatings Technol. 2016, 304, 160–166. [Google Scholar] [CrossRef]
- Malshe, P.; Mazloumpour, M.; El-Shafei, A.; Hauser, P. Multi-functional military textile: Plasma-induced graft polymerization of a C6 fluorocarbon for repellent treatment on nylon–cotton blend fabric. Surf. Coatings Technol. 2013, 217, 112–118. [Google Scholar] [CrossRef]
- Attia, N.F.; Mousa, M. Synthesis of smart coating for furniture textile and their flammability and hydrophobic properties. Prog. Org. Coatings 2017, 110, 204–209. [Google Scholar] [CrossRef]
- Hebeish, A.; El-Naggar, M.; Fouda, M.M.; Ramadan, M.A.; Al-Deyab, S.S.; El-Rafie, M. Highly effective antibacterial textiles containing green synthesized silver nanoparticles. Carbohydr. Polym. 2011, 86, 936–940. [Google Scholar] [CrossRef]
- Xu, Q.; Xie, L.; Diao, H.; Li, F.; Zhang, Y.; Fu, F.; Liu, X. Antibacterial cotton fabric with enhanced durability prepared using silver nanoparticles and carboxymethyl chitosan. Carbohydr. Polym. 2017, 177, 187–193. [Google Scholar] [CrossRef] [PubMed]
- El-Shafei, A.; Okeil, A. ZnO/Carboxymethyl chitosan bionano-composite to impart antibacterial and UV protection for cotton fabric. Carbohydr. Polym. 2011, 83, 920–925. [Google Scholar] [CrossRef]
- Attia, N.F.; Morsy, M.S. Facile synthesis of novel nanocomposite as antibacterial and flame-retardant material for textile fabrics. Mater. Chem. Phys. 2016, 180, 364–372. [Google Scholar] [CrossRef]
- Cheema, H.; El-Shafei, A.; Hauser, P.J. Conferring flame retardancy on cotton using novel halogen-free flame retardant bifunctional monomers: Synthesis, characterizations and applications. Carbohydr. Polym. 2013, 92, 885–893. [Google Scholar] [CrossRef]
- Hassan, M.; Hammoda, H.; Salah, A.; Attia, N. Thermal Analysis Techniques as a Primary Sign for Fire Retardancy of New Textile Back-coating Formulations. J. Ind. Text. 2010, 39, 357–376. [Google Scholar] [CrossRef]
- Elashery, S.E.A.; Frag, E.Y.; Mousa, M.G. A comparative study of tetra-n-butylammonium bromide potentiometric selective screen printed, carbon paste and carbon nanotube modified graphite sensors. J. Iran. Chem. Soc. 2019, 17, 911–921. [Google Scholar] [CrossRef]
- Liu, Y.; Zhao, J.-C.; Zhang, C.-J.; Cui, L.; Guo, Y.; Zhu, P.; Zhang, H.; Zheng, Z.-W.; Wang, D. Flame retardancy and thermal degradation properties of cotton/alginate fabric. J. Therm. Anal. Calorim. 2016, 127, 1543–1551. [Google Scholar] [CrossRef]
- Xu, Q.; Ke, X.; Shen, L.; Ge, N.; Zhang, Y.; Fu, F.; Liu, X. Surface modification by carboxymethy chitosan via pad-dry-cure method for binding Ag NPs onto cotton fabric. Int. J. Boil. Macromol. 2018, 111, 796–803. [Google Scholar] [CrossRef]
- Attia, N.F.; Moussa, M.; Sheta, A.M.; Taha, R.; Gamal, H. Effect of different nanoparticles-based coating on the performance of textile properties. Prog. Org. Coatings 2017, 104, 72–80. [Google Scholar] [CrossRef]
- Mathew, B.P.; Kumar, A.; Sharma, S.; Shukla, P.; Nath, M. An eco-friendly synthesis and antimicrobial activities of dihydro-2H-benzo- and naphtho-1,3-oxazine derivatives. Eur. J. Med. Chem. 2010, 1502–1507. [Google Scholar] [CrossRef] [PubMed]
- Elashery, S.E.; Attia, N.F.; Omar, M.M.; Tayea, H.M. Cost-effective and green synthesized electroactive nanocomposite for high selective potentiometric determination of clomipramine hydrochloride. Microchem. J. 2019, 151, 104222. [Google Scholar] [CrossRef]
- Habib, O.M.O.; Hassan, A.E.-M.H.M.; Hassan, H.M.; El-Meka, A. Studies on Some Benzoxazine-4-one Derivatives with Potential Biological Activity. Am. J. Org. Chem. 2012, 2, 45–51. [Google Scholar] [CrossRef]
- Khan, Z.A.; Naqvi, S.A.R.; Shahzad, S.A.; Mahmood, N.; Yar, M.; Zahoor, A.F. Synthesis and Antimicrobial Activity of 2-Aryl-4H-3,1-benzoxazin-4-ones. Asian J. Chem. 2013, 25, 152–156. [Google Scholar] [CrossRef]
- El-Hashash, M.A.E.-A.; Azab, M.E.; Faty, R.A.E.-A.; Amr, A.E.-G.E. Synthesis, Antimicrobial and Anti-inflammatory Activity of Some New Benzoxazinone and Quinazolinone Candidates. Chem. Pharm. Bull. 2016, 64, 263–271. [Google Scholar] [CrossRef]
- Deshmukh, M.; Suryawanshi, A.; Mali, A.; Dhongade, D.S. New Route to Synthesis and QSAR Study of 1,2,4-Aryl Substituted Triazoles. Synth. Commun. 2004, 34, 2655–2658. [Google Scholar] [CrossRef]
- Madkour, H. Reactivity of 4H-3,1-benzoxazin-4-ones towards nitrogen and carbon nucleophilic reagents: Applications to the synthesis of new Heterocycles. Arkivoc 2004, 36. [Google Scholar] [CrossRef]
- Nowakowska, Z. A review of anti-infective and anti-inflammatory chalcones. Eur. J. Med. Chem. 2007, 42, 125–137. [Google Scholar] [CrossRef] [PubMed]
- Bandgar, B.P.; Gawande, S.S.; Bodade, R.G.; Totre, J.V.; Khobragade, C.N. Synthesis and biological evaluation of simple methoxylated chalcones as anticancer, anti-inflammatory and antioxidant agents. Bioorganic Med. Chem. 2010, 18, 1364–1370. [Google Scholar] [CrossRef]
- Sahu, N.K.; Balbhadra, S.S.; Choudhary, J.; Kohli, D.V. Exploring pharmacological significance of chalcone scaffold: A review. Curr. Med. Chem. 2012, 19, 209–225. [Google Scholar] [CrossRef] [PubMed]
- Malucelli, G. Sol-Gel and Layer-by-Layer Coatings for Flame-Retardant Cotton Fabrics: Recent Advances. Coatings 2020, 10, 333. [Google Scholar] [CrossRef]
- Tadesse, M.; Mengistie, D.A.; Chen, Y.; Wang, L.; Loghin, C.; Nierstrasz, V. Electrically conductive highly elastic polyamide/lycra fabric treated with PEDOT: PSS and polyurethane. J. Mater. Sci. 2019, 54, 9591–9602. [Google Scholar] [CrossRef]
- Tadesse, M.; Loghin, C.; Chen, Y.; Wang, L.; Catalin, D.; Nierstrasz, V. Effect of liquid immersion of PEDOT: PSS-coated polyester fabric on surface resistance and wettability. Smart Mater. Struct. 2017, 26, 065016. [Google Scholar] [CrossRef]
- Attia, N.F.; El Ebissy, A.A.; Hassan, M. Novel synthesis and characterization of conductive and flame-retardant textile fabrics. Polym. Adv. Technol. 2015, 26, 1551–1557. [Google Scholar] [CrossRef]
- Attia, N.F.; Moussa, M.; Sheta, A.M.; Taha, R.; Gamal, H. Synthesis of effective multifunctional textile based on silica nanoparticles. Prog. Org. Coatings 2017, 106, 41–49. [Google Scholar] [CrossRef]
- Papa, D.; Schwenk, E.; Villani, F.; Klingsberg, E. β-Aroylacrylic Acids. J. Am. Chem. Soc. 1948, 70, 3356–3360. [Google Scholar] [CrossRef]
- Abdel-Fattah, M.; Soliman, E.; Soliman, S. Synthesis and reactions of 2- [2- (2, 4, 6-trimethylbenzoyl) vinyl] -4H-3, 1-benzoxazin-4-one of expected biological activity. Egypt J. Chem. 1999, 42, 499–516. [Google Scholar]
- AATCC-147—Test Method. Antibacterial Activity Assessment of Textile Materials Parallel Streak methods: Parallel Streak Method; American Association of Textile Chemists and Colorists: Research Triangle Park, NC, USA, 2004. [Google Scholar]
- ISO Standard Test. Determination of Burning Behaviour of Interior Materials; International Organization for Standardization: Geneva, Switzerland, 1989. [Google Scholar]
- Elsayed, E.M.; Attiab, N.F.; Alshehria, L.A. Innovative Flame Retardant and Antibacterial Fabrics Coating Based on Inorganic Nanotubes. Chem. Select. 2020, 5, 2961–2965. [Google Scholar] [CrossRef]
- Dong, C.; He, P.; Lu, Z.; Wang, S.; Sui, S.; Liu, J.; Zhang, L.; Zhu, P. Preparation and properties of cotton fabrics treated with a novel antimicrobial and flame retardant containing triazine and phosphorus components. J. Therm. Anal. Calorim. 2017, 131, 1079–1087. [Google Scholar] [CrossRef]

| Sample Code | Chitosan Mass Loading (CH) (wt.%) | Organic Agent Mass Loadings (OA) (wt.%) | Add On (%) |
|---|---|---|---|
| T | 0 | 0 | 0 |
| CH-T | 100 | 0 | 10 |
| T-CH-OA-20 | 80 | 20 | 15 |
| T-CH-OA-50 | 50 | 50 | 20 |
| T-CH-OA-60 | 40 | 60 | 20 |
| Sample Code | (a) T20%/°C | (b) Ton/°C | (c) T50%/°C | (d) Char Residue wt.% |
|---|---|---|---|---|
| Blank | 325 | 391 | 414 | 14 |
| T–CH | 339 | 393 | 420 | 14.7 |
| T–CH–OA–20 | 325 | 395 | 415 | 17.2 |
| T–CH–OA–50 | 330 | 397 | 423 | 18 |
| Sample Code | Rate of Burning (mm/min) | LOI (%) |
|---|---|---|
| Blank | 118 | 18.2 |
| T–CH | 90 | 19.3 |
| T–CH–OA–20 | 45 | 21 |
| T–CH–OA–50 | 0 | 23.8 |
| Sample Code | Tensile Strength (N) | Elongation (%) |
|---|---|---|
| Blank | 535 ± 4 | 29 ± 1.4 |
| T–CH | 759 ± 3 | 6 ± 0.4 |
| T–CH–OA–20 | 625 ± 44 | 8 ± 1.6 |
| T–CH–OA–50 | 811 ± 44 | 12 ± 4 |
| T–CH–OA–60 | 782 ± 23 | 16 ± 4 |
| Sample Code | Average Width of Clear Inhibition Zone (mm) |
|---|---|
| T | 0 |
| T–CH | 0 |
| T–CH–OA–20 | 0 |
| T–CH–OA–50 | 12.3 |
| T–CH–OA–60 | 18 |
© 2020 by the authors. Licensee MDPI, Basel, Switzerland. This article is an open access article distributed under the terms and conditions of the Creative Commons Attribution (CC BY) license (http://creativecommons.org/licenses/by/4.0/).
Share and Cite
Attia, N.F.; Soliman, M.H.; El-Sakka, S.S. Facile Route for Synthesis of Novel Flame Retardant, Reinforcement and Antibacterial Textile Fabrics Coatings. Coatings 2020, 10, 576. https://doi.org/10.3390/coatings10060576
Attia NF, Soliman MH, El-Sakka SS. Facile Route for Synthesis of Novel Flame Retardant, Reinforcement and Antibacterial Textile Fabrics Coatings. Coatings. 2020; 10(6):576. https://doi.org/10.3390/coatings10060576
Chicago/Turabian StyleAttia, Nour F., Mohamed H. Soliman, and Sahar S. El-Sakka. 2020. "Facile Route for Synthesis of Novel Flame Retardant, Reinforcement and Antibacterial Textile Fabrics Coatings" Coatings 10, no. 6: 576. https://doi.org/10.3390/coatings10060576
APA StyleAttia, N. F., Soliman, M. H., & El-Sakka, S. S. (2020). Facile Route for Synthesis of Novel Flame Retardant, Reinforcement and Antibacterial Textile Fabrics Coatings. Coatings, 10(6), 576. https://doi.org/10.3390/coatings10060576

